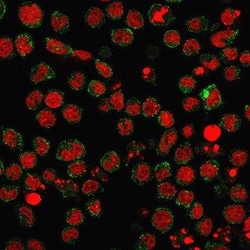
SSEA-1 Antibody (FUT4/1478R) - Azide and BSA Free, Novus Biologicals 0.1

missing translation for 'onlineSavingsMsg'
Learn More
Learn More
SSEA-1 Antibody (FUT4/1478R) - Azide and BSA Free, Novus Biologicals™
Rabbit Monoclonal Antibody
Marke: Novus Biologicals NBP2-49879-0.1mg
Dieser Artikel kann nicht zurückgegeben werden.
Rückgaberichtlinie anzeigen
Beschreibung
SSEA-1 Monoclonal antibody specifically detects SSEA-1 in Human, Mouse, Rat samples. It is validated for Flow Cytometry, Immunohistochemistry, Immunocytochemistry/ Immunofluorescence, Immunohistochemistry (Paraffin), Immunofluorescence, CyTOF
Spezifikation
| SSEA-1 | |
| Monoclonal | |
| 1.0 mg/mL | |
| Flow Cytometry 0.5-1ug/million cells, Immunohistochemistry, Immunocytochemistry/ Immunofluorescence, Immunohistochemistry-Paraffin 0.5-1.0ug/mL, Immunofluorescence 0.5-1ug/mL, CyTOF-ready | |
| alpha-(1,3)-fucosyltransferase, CD15, EC 2.4.1, EC 2.4.1.-, EC 2.4.1.65, ELAM-1 ligand fucosyltransferase, ELFT, FCT3AELAM ligand fucosyltransferase, Fucosyltransferase 4, fucosyltransferase 4 (alpha (1,3) fucosyltransferase, myeloid-specific), Fucosyltransferase IV, fucT-IV, FUC-TIV, FUTIV, Galactoside 3-L-fucosyltransferase, Lewis X, LeX, SSEA-1, stage-specific embryonic antigen 1 | |
| Recombinant human full-length SSEA-1 protein (Uniprot: P22083) | |
| 0.1 mg | |
| Cellular Markers, Endothelial Cell Markers, Hematopoietic Stem Cell Markers, Immunology, Pancreatic Stem Cell Markers, Stem Cell Markers | |
| 2526 | |
| Store at -20°C to -80°C. Avoid freeze-thaw cycles. | |
| IgG |
| Flow Cytometry, Immunohistochemistry, Immunofluorescence, Immunohistochemistry (Paraffin), Immunofluorescence | |
| FUT4/1478R | |
| Unconjugated | |
| 10 mM PBS | |
| Rabbit | |
| Protein A purified | |
| RUO | |
| Primary | |
| Human, Mouse, Rat | |
| Purified |
Berichtigung von Produktinhalten
Bitte geben Sie uns Ihr Feedback zu den Produktinhalten, indem Sie das folgende Formular ausfüllen.
Name des Produkts
Haben Sie Verbesserungsvorschläge?Übermitteln Sie eine inhaltliche Korrektur